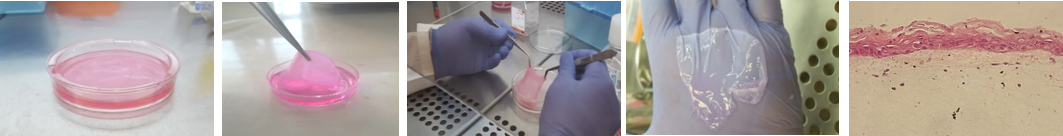
تولیدصنعتی محصول پوست دولایه

تولیدصنعتی محصول پوست دولایه
کاربردها و مصارف:درمان زخمهای ایجاد شده در پوست بویژه زخم دیابتی
نام واحد:پژوهشگاه رویان
نحوه تماس و ثبت سفارش:www.royaninstitute.org
مصرف کنندگان:بیماران دارای زخم های دیابتی
گروه های استفاده کنندگان(گیرندگان خدمات):
اطلاعات هماهنگ کننده:23562000
اهداف اجرای طرح ( مشکلات، نیازهای موجود در جامعه، صرفه جویی ارزی، .......):
- تولید صنعتی محصول GMP-gradeبا قابلیت پیوند به انسان طبق استانداردهای بین المللی
- ایجاد زیرساخت برای توسعه محصولات پیشرفته مهندسی شده قابل صادرات به کشورهای منطقه
- خروجی و دستاوردهای حاصل از اجرای پروژه:
ایجاد بانک آلوژن سلولهای فیبروبلاست و کراتینوسیت
- کاربرد:
درمان زخمهای ایجاد شده در پوست بویژه زخم دیابتی.
دیابت (diabetes)، بزرگترین اپیدمی قرن که در حال حاضر سریعترین رشد را دارد. افراد دیابتی به دلیل قند خون بالا در طولانی مدت مستعد مشکلات متعددی از جمله پای دیابتی هستند. نوروپاتی یکی از مشکلات اصلی در پای افراد دیابتی است. به دنبال نوروپاتی، افراد دیابتی زخمهای وارد شده به پاها را احساس نمیکنید و به همین دلیل آسیب می تواند پیشروی کرده و حتی باعث ایجاد عفونت شود. از طرفی دیگر کاهش جریان خون میتواند موجب درد، عفونت و کاهش بهبود زخم ها شود. عفونت شدید گاهی نیز موجب بد شکلی های پا و در نهایت قطع اندام میشود.درمانهای رایج برای زخم پای دیابتی، شامل 1- دارودرمانی است که بیشتر شامل آنتی بیوتیک ها و مسکن ها است. 2- درمانهای موضعی ازجمله، پانسمان های حاوی نقره یا کرمهای سولفادیازین نقره، ژل یا محلول پلی هگزامتیلن بیگوآنید (PHMB)، ید و عسل پزشکی در فرم پماد یا ژل. و 3- درمانهای مبتنی بر جراحی است که باعث کاهش فشار و عفونت ایجاد شده در اطراف زخم می شود.
علی رقم درمانهای موجود هر5 دقیقه یک قطع عضو در بیماران مبتلا به دیابت در دنیا رخ می دهد. در ایران بیماری دیابت شیوع نسبتا بالایی دارد ( 1.5 میلیون نفر) که به این جمعیت هر سال 200هزار نفر افزوده میشود و 5% از افراد دیابتی در ایران دچار قطع عضو می شوند. بنابراین روشهای نوین برای درمان زخم دیابتی وارد عمل شدند که در این روشها از پوستهای مهندسی شده برای پوشاندن سطح زخم استفاده میشود که باعث کوتاه تر شدن زمان ترمیم میشود.
در طرح حاضر با استفاده از تکنولوژی مهندسی بافت، دو نوع سلول کراتینوسیت و فیبروبلاست را بر سطح ژل کلاژن کاشته و پوست دولایه حاصل شده است.
دستاوردهای حاصل از اجرای طرح:
سلولهای فیبروبلاست و کراتینوسیت مورد نیاز برای تولید پوست دولایه به صورت انبوه کشت داده شده و در بانک سلولی نکهداری شده اند. همچنین تولید آزمایشی پوست دولایه نیز انجام شده و مطالعه حیوانی آن در حال انجام است. محصول نهایی با نام روی اسکین ( RoySkin) به بازار عرضه خواهد شد.
وضعیت تولیدمحصول/فناوری در دنیا و جایگاه ایران در این موضوع:
محصولات پوست مهندسی شده در دنیا جزء اولین محصولات مهندسی بافتی هستند که در بازار عرضه شدند. و از شرکتهای پیشرو در این زمینه شرکت آمریکایی ارگانوژنز است که با هدف تقویت توان بهبودی از طریق توسعه، تولید و فروش محصولات برای مراقبت از زخم و بازارهای پزشکی و جراحی در سال 1985 تاسیس شد. یکی از محصولات معروف این شرکت پوست دولایه با نام تجاری اپلیگرفت ( Apligraft) است. که قیمت هر واحد آن 1000-1200 دلار است.
محصول نهایی مرکز ATMP رویان از نظر مشخصات فنی با Apligraft کاملا مشابه است. و با تولید انبوه این محصول مطمئنا قیمتی کمتر خواهد داشت و در نهایت برای بیماران دیابتی داخل کشور و حتی کشورهای مجاور استفاده خواهد شد.
جایگاه طرح به لحاظ سطح فناوری:
مهندسی بافت جز، روشهای نوین در دنیا محسوب میشود بنابراین تولید محصولات مهندسی بافت با رعایت پروتوکل های بینالمللی GMP جزء فناوری پیشرفته دسته بندی میشود.
مشخصات فنی:
این محصول از فیبروبلاستهای کشت شده در ماتریکس مشتق از کلاژن نوع 1 گاوی است که سلولهای کراتینوسایت روی این فیبروبلاستها قرار گرفته و پس از رشد، یک جایگزین پوست دو لایه را به وجود میآورند. این محصول با توجه به دارا بودن سلول های زنده، از کارآیی بیشتری نسبت به محصولات مشابه پوستی برخوردار است.
این محصول با تولید مقدار زیادی سایتوکاین و فاکتور رشد، تمایز و تکثیر را در بسترهای زخم مزمن و درمان ناپذیر، میسر میکند و این زخمها با سرعتی بیشتر بهبود مییابند و کمتر دچار فیبروز میشوند. این توانایی احتمالاً به وجود فیبروبلاستها و کراتینوسایتهای به دست آمده از پوست نوزاد ارتباط دارد که به دلیل جوان بودن، باعث تحریک زخم به سمت درمان میشوند.
ارسال نظر برای این محصول مجاز نیست.


